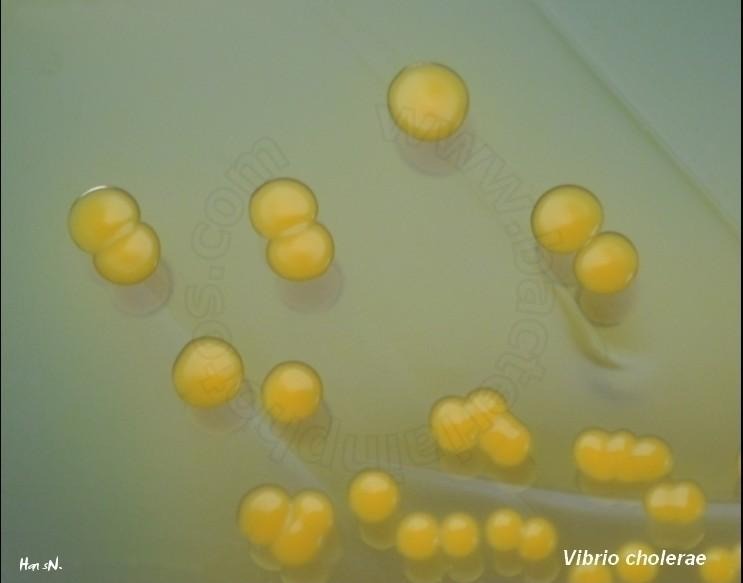
image 26 image 26
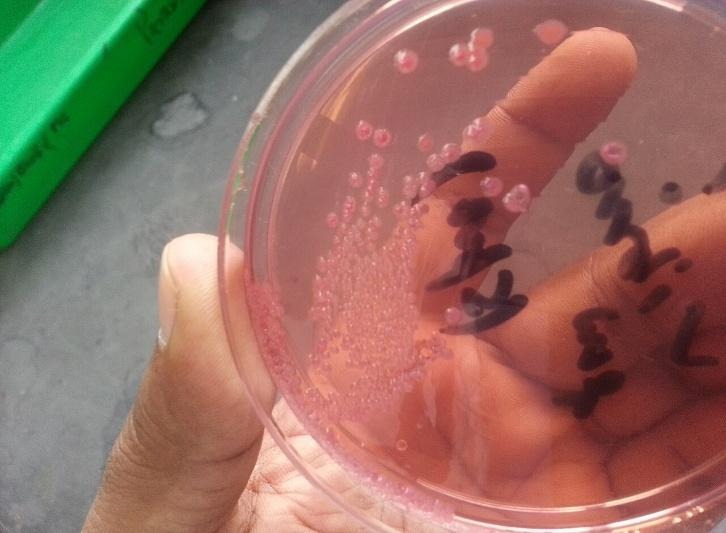
image 27 image 27

Cholera, a bacterial infection, has led to multiple epidemics and pandemics throughout history. Cholera is caused by the bacterium Vibrio cholerae. Vibrio cholerae was first isolated in 1883 by Robert Koch. Since 1817, seven cholera pandemics have been registered worldwide.

The first pandemic that was seen worldwide was caused by the V. cholerae O1 biotype, and the seventh was caused by the El Tor biotype, which persists to date. V. cholerae O139 emerged later in 1992 in India and Bangladesh. John Snow, an English physician, demonstrated that cholera was transmitted through contaminated water in 1854.
Taxonomy and Classification of Vibrio cholerae
Taxonomy of Vibrio cholerae :
| Domain | Bacteria |
| Phylum | Proteobacteria |
| Class | Gammaproteobacteria |
| Order | Vibrionales |
| Family | Vibrionaceae |
| Genus | Vibrio |
| Species | Vibrio cholerae |
On the basis of its O cell wall antigens, Vibrio cholera is divided into three serotypes. They are O1, O139 and Non-O1. Among these serotypes, O1 and O139 are pathogenic in nature and cause cholera, while Non-O1 is non-pathogenic or sporadic.
O1
There are two biotypes of O1. Biotypes are based on differences in biochemical reactions.
- Classical
- El Tor
There are three serotypes of 01. Serotypes are based on antigenic differences.
- Ogawa
- Inaba
- Hikojima
Morphology and Microscopy of Vibrio cholerae
Vibrio cholerae is a Gram-negative bacillus that measures about 1.5µm in length and 0.2-0.4µm in width. The cells of Vibrio cholera are short, curved rods (commonly described as comma-shaped) with slightly pointed or rounded ends. The bacterium is non-spore-forming, non-capsulated, and non-halophilic ( an organism that can grow in media without added salt).
Due to the presence of a single polar flagellum, the organisms are actively motile. Since the organisms show rapid and directional movement, like shooting across the place, this movement is called ‘darting motility’. Koch further described the movement as “fish in a stream”.
Cultural and Growth Characteristics of Vibrio cholerae
Vibrio cholerae are facultative anaerobes that grow best on ordinary alkaline medium. It can grow at a temperature range between 16𑇑C to 60𑇑C and pH between 6.4 and 9.6. However, the optimum temperature is 37𑇑C while the pH is 8.2. As they are non-halophilic, they can only grow in media that contains up to 7% sodium chloride, not higher than that.
- Alkaline Nutrient Agar: The colonies on the alkaline nutrient agar appear to be moist, translucent, and round disks (that measure 1-2mm in diameter). When viewed under transmitted light, they have a bluish tint and emit a unique odour.
- MacConkey Agar: As Vibrio cholerae are late lactose fermenters, on prolonged incubation, V. cholerae form reddish-colored colonies on MacConkey’s agar.
- Blood Agar: A greenish decolourisation is seen around the colonies and becomes clear later due to haemodigestion.
- Thiosulphate Citrate Bile Sucrose Agar: Thiosulphate citrate bile sucrose agar is the most widely used and cost-effective agar for the isolation of V. cholerae. The pH indicator of this agar is bromothymol blue. V. cholerae ferments sugar, which turns bromothymol blue yellow, making the colonies convex and yellow.
- Alkaline Peptone Water (APW): Within 6 hours after incubation at 37𑇑C, a surface pellicle growth is seen in alkaline peptone water, which breaks on shaking. Alkaline peptone water consists of peptone, sodium chloride, and distilled water, and has a high pH (8.5-9.0).
String Test: For the identification of V. cholerae, the string test can also be used. A loopful of colonies is taken and mixed with 0.5% sodium deoxycholate on a glass slide. They are then mixed. If the formation of a mucoid string of 5mm is seen, the organism is detected (the test is positive). Formation of a mucoid string is due to cell lysis, which releases DNA.

Biochemical and Identification Tests of Vibrio cholerae
The biochemical characteristics of Vibrio cholera can be listed as:
| S.N | Biochemical Characteristics | Vibrio cholerae |
| 1. | Oxidase | Positive |
| 2. | Urease | Negative |
| 3. | Citrate | Positive |
| 4. | Motility | Motile |
| 5. | MR (Methyl Red) | Negative |
| 6. | VP( Voges Proskauer) | Variable |
| 7. | Indole | Positive |
| 8. | Catalase | Positive |
| 9. | Nitrate Reduction | Positive |
| 10. | H2S Production | Negative |
| 11. | Glucose Fermentation | Positive |
| 12. | Sucrose Fermentation | Positive |
| 13. | Lactose Fermentation | Variable |
Pathogenesis of Vibrio cholerae
Cholera is caused by the consumption of contaminated food and water. As the organism is sensitive to gastric acid, individuals with low gastric acid are more susceptible to infection. Some of the organisms survive the acidic environment and reach the small intestine. There, they attack the epithelial cells of the intestine using pili.
After colonisation, V. cholerae produces cholera toxins, which are responsible for the symptoms of the disease. The cholera toxins have two main parts: 1. A subunit (active portion) and 2. B subunit (binding portion). The B subunit binds to the GM1 ganglioside receptor on the intestinal epithelial cell and allows the A subunit to enter the cell. Inside the cell, A subunit activates adenylate cyclase by altering the G protein. This leads to a significant increase in cyclic AMP (cAMP). Elevated cAMP levels cause excessive secretion of chloride ions, sodium, and water to the intestinal lumen. It results in watery diarrhea that causes dehydration and hypotension. The bacteria that are excreted in large numbers in stool can contaminate water sources. The cycle of transmission continues.
Epidemiology and Transmission of Vibrio cholerae
Cholera is generally transmitted due to the ingestion of contaminated food or water. Since cholera is highly communicable, it can also be transmitted from one person to another. Therefore, when a person is infected, they can spread the infection to another individual through the faecal-oral route. If the infected individual’s excreted stool enters a water supply, the water supply gets contaminated, and another individual consuming that water gets infected. Consumption of raw food or undercooked seafood can also transmit cholera.
Clinical Manifestation of Vibrio cholerae
The key symptoms of cholera are:
- Diarrhoea
- Vomiting
- Dehydration
- Fatigue
- Low blood pressure
- Loss of body weight
Frequent loose motion of about 1liter of fluid is seen in adults. The stool appears to be pale and milky in appearance, like rice rinsed water, so it is also described as a “rice water” stool. Due to continued diarrhea, patients experience nausea, extreme thirst, dry mouth and skin, chills, no urination, and irregular heartbeat. If the symptoms are not treated, it can also lead to the death of the patients due to hypovolemic shock.
Laboratory Diagnosis of Vibrio cholerae
Vibrio cholera is detected from clinical samples using a microscope, culture, biochemical tests, and serological methods.
- Sample collection: A sample of fresh stool is collected using a sterile container. The sample is then transported to the laboratory as quickly as possible; if not, Cary Blair medium is used for transportation.
- Culture: The collected sample is then cultured into TCBS (Thiosulfate Citrate Bile Sucrose) Agar, Nutrient Agar, MacConkey Agar, and Blood Agar. It is then incubated at 37°C for 24 hours.
- Biochemical test: After the formation of colonies, biochemical tests like oxidase, catalase, motility, Voges-Proskauer (VP), indole, and citrate are performed.
- Antibiotic susceptibility test: AST is usually performed by using the Kirby-Bauer disk diffusion method. Bacterial culture is spread around the Muller-Hinton agar, and antibiotic discs are placed in it. After 24 hours of incubation, a zone of inhibition is seen around the disk. The zone is measured for the determination of susceptibility.
- String Test: This test is performed to distinguish Vibrio from other groups. A loopful of colonies is mixed with0.5% sodium deoxycholate on a glass slide. If the formation of a mucoid string is seen, V. cholera is detected.
During epidemic settings, Rapid Diagnostic Test (RDT) kits are useful but not for routine diagnosis. Since they do not produce an isolate for testing antimicrobial susceptibility and subtyping
Antimicrobial Resistance of Vibrio cholerae
Antimicrobial resistance in Vibrio cholera has been increasingly reported, raising public health concerns. Over the years, resistance to Ampicillin, Tetracycline, Fluoroquinolones (ciprofloxacin), and macrolides (azithromycin) has been rising.
Prevention and Control of Vibrio cholerae Infections
Vibrio cholera poses a major public health issue as it can lead to pandemics. Hence, many strategies have been planned to eliminate the endemic or pandemic cholera. Cholera can be prevented and controlled by:
- Improving the quality of water by increasing purification facilities.
- Early detection of cases and adequate treatment
- Use of latrines and proper sanitary methods for sewage disposal
- Providing health education promoting awareness
- Monitoring and surveillance of cholera cases
Treatments of Vibrio cholerae Infections
In the management of cholera cases, rehydration is one of the major steps. As promoted by the WHO, Oral Rehydration Therapy is used for treating dehydration during cholera. Consumption of Oral rehydration solution (ORS) (constituent of sodium chloride, potassium chloride, trisodium citrate, and glucose) by dissolving in 1litre of drinking water.
Another step is Antibiotic Therapy. Antibiotics like Tetracycline or doxycycline reduce the stool output and the period of excretion of V. cholerae. Other commonly used antibiotics are ciprofloxacin and norfloxacin.
Conclusion
Vibrio cholera is a waterborne pathogen that causes cholera. Cholera is a watery diarrhoea illness that can be fatal if not treated. Early diagnosis, oral dehydration treatment, suitable antibiotic treatments, good sanitation, safe drinking water, and public health surveillance help reduce the illness and death rate. Even with the progress in the treatment and prevention, cholera remains a public health issue in many of the developing countries, reflecting the necessity for a better healthcare system.
Reference
- Chakraborty, P. (2005). A Textbook Of Microbiology. New Central Book Agency (P) Limited.
- Cholera. (2024, December 5). World Health Organisation (WHO). https://www.who.int/news-room/fact-sheets/detail/cholera
- Cholera | Cholera. (2025, May 29). CDC. Retrieved February 12, 2026, from https://www.cdc.gov/cholera
- Chowdhury, F., Ross, A. G., Islam, M. T., McMillan, N. A.J., & Qadri, F. (2022). Diagnosis, Management, and Future Control of Cholera. https://doi.org/10.1128/cmr.00211-21
- Greenwood, D. (Ed.). (2007). Medical Microbiology: A Guide to Microbial Infections: Pathogenesis, Immunity, Laboratory Diagnosis and Control. Churchill Livingstone/Elsevier.
- Panjarathinam, R. (2007). Medical Microbiology. New Age International (P) Limited.
- Rodriguez, J. A. O., Hashmi, M. F., & Kahwaji, C. I. (2024, May 1). Vibrio cholerae Infection – StatPearls – NCBI Bookshelf. NCBI. https://www.ncbi.nlm.nih.gov/books/NBK526099/